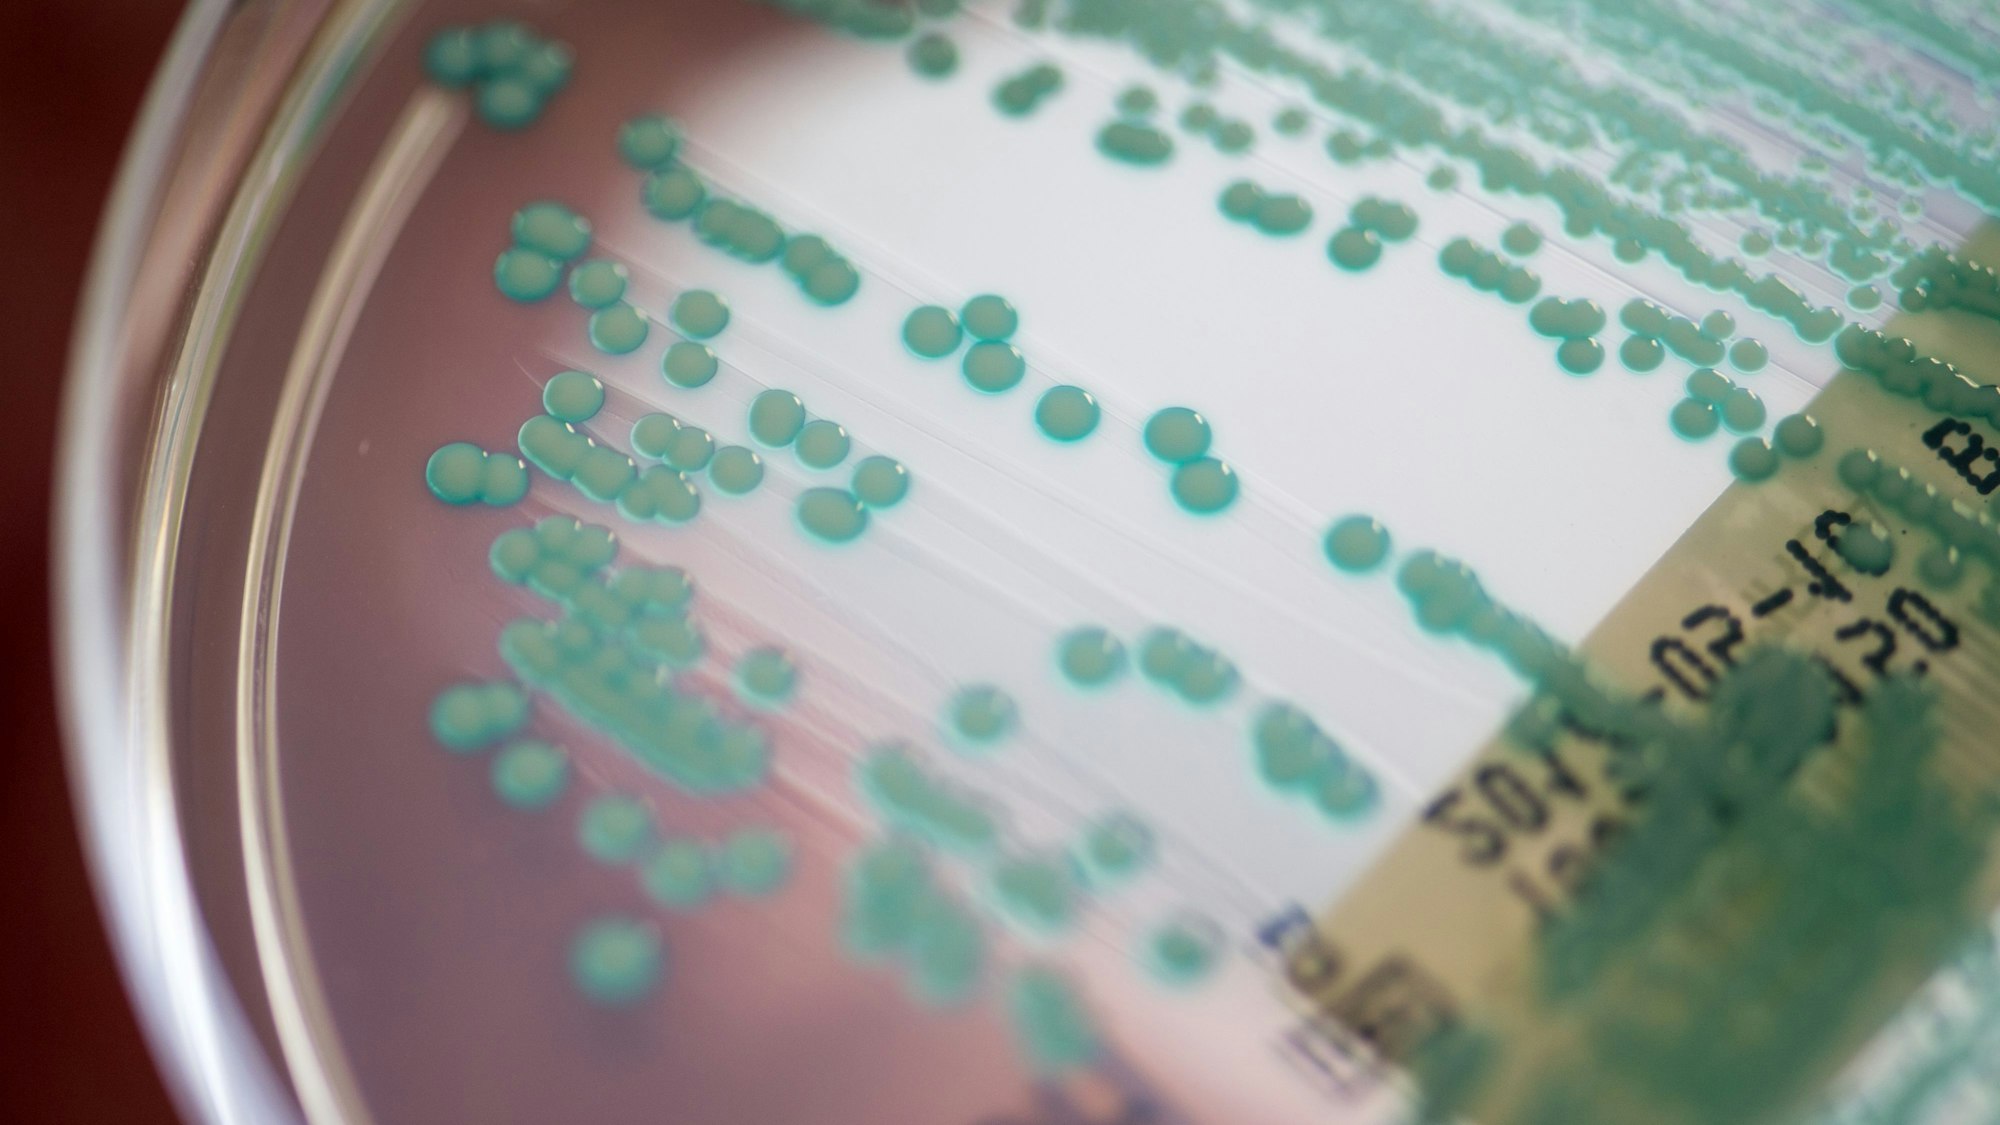
Eine Petrischale mit MRSA-Keimen

Bis ein neues Antibiotikum beim Menschen zum Einsatz kommen kann, dauert es meist um die zehn Jahre.
Erfolgreich gegen KrankenhauskeimeBonner Expertenteam entdeckt neues, hochwirksames Antibiotikum
Forscher haben ein neues Antibiotikum entdeckt und seine Wirkweise aufgeklärt. (Symbolbild)
Copyright: Armin Weigel/dpa
Noch vor zwei Jahren hatte Tanja Schneider ihren Job im Gespräch mit der Redaktion als besondere Variante des Hase-und-Igel-Wettlaufs bezeichnet. Wobei sie sich und ihre Kollegen zum Team des ausgetricksten Tieres mit den langen Ohren zählte.
Die Professorin für Pharmazeutische Mikrobiologie an der Uni und dem Uniklinikum Bonn forscht zur Entwicklung neuer Antibiotika. Eine schwierige Aufgabe – auch weil immer mehr bakterielle Krankheitserreger Resistenzen gegen die einstigen Wundermittel entwickeln. So nimmt die Gefahr zu, dass gängige Medikamente nicht mehr wirken gegen Infektionskrankheiten. Deswegen sucht die Wissenschaft weltweit nach neuen Wirkstoffen.
Bei dieser Suche haben Schneider und ihr Team nun einen Erfolg erzielt. Mit Kollegen aus Deutschland, den Niederlanden und den USA haben sie ein neues Antibiotikum entdeckt und seine Wirkweise aufgeklärt: Clovibactin stammt von einem Bodenbakterium und attackiert die Zellwand von Bakterien, auch die von multiresistenten „Krankenhauskeimen“.
Neues Antibiotikum zerstört Zellhülle
Das Bodenbakterium Eleftheria terrae subspecies carolina trägt seinen Herkunftsort im Namen: Wissenschaftler hatten es aus einer Bodenprobe im US-Bundesstaat North Carolina isoliert. Es produziert den neuen Wirkstoff Clovibactin, um sich vor konkurrierenden Bakterien zu schützen. „Das neue Antibiotikum attackiert gleichzeitig an mehreren Stellen den Aufbau der bakteriellen Zellwand, indem es essenzielle Bausteine blockiert“, erklärt Schneider. Mit ungewöhnlicher Intensität heftet es sich gezielt an diese Bausteine und tötet die Bakterien, indem es ihre Zellhülle zerstört. Da es die Zielstruktur wie ein Käfig umschließt, erhielt es den Namen „Clovibactin“, abgeleitet vom griechischen „klouvi“ (Käfig).
Clovibactin wirkt vor allem auf grampositive Bakterien. Dazu zählen die als „Krankenhauskeime“ bekannten MRSA (Methicillin-resistenter Staphylococcus aureus), aber auch Erreger der Tuberkulose, an der weltweit viele Millionen Menschen erkranken.
„Wir sind sehr zuversichtlich, dass die Bakterien nicht so schnell Resistenzen gegen Clovibactin entwickeln“, sagt Schneider. Denn die Erreger können die Zellwandbausteine nicht so leicht verändern, um das Antibiotikum zu unterlaufen – ihre Achillesferse bleibt damit bestehen.
Noch viele Studien nötig
Doch die Wissenschaftler haben herausgefunden, dass Clovibactin noch mehr kann. Nach dem Andocken an das Ziel bildet das Antibiotikum faserartige Strukturen aus, die den „Gegner“ fest umschließen und die Bakterienzellen weiter schädigen. Bakterien, die auf Clovibactin treffen, werden außerdem dazu angeregt, bestimmte Enzyme freizusetzen (sogenannte Autolysine), die unkontrolliert die eigene Zellhülle auflösen. „Die Kombination dieser verschiedenen Mechanismen ist der Grund für die außergewöhnliche Widerstandsfähigkeit gegenüber Resistenzen“, resümiert Schneider.
Bis ein neues Antibiotikum beim Menschen zum Einsatz kommen kann, dauert es erfahrungsgemäß rund zehn Jahre, so Schneider. „Nach Entdeckung braucht es viele klinische Studien und etwa eine Milliarde Euro.“
Ein Problem dabei: Von ursprünglich etwa 20 großen Pharma-Unternehmen, die in der Antibiotika-Forschung in der Vergangenheit tätig waren, sind noch vier Firmen weltweit übrig geblieben. Warum? „Es ist für die Firmen nicht lukrativ genug“, erklärt Schneider. „Ein Antibiotikum nehmen Sie sieben Tage lang, dann sind Sie wieder gesund. Einen Cholesterin-Senker nehmen Sie langfristig. Und natürlich haben auch die Unternehmen Sorge, dass sich weitere Resistenzen gegen Antibiotika bilden und sie damit wirkungslos würden.“
